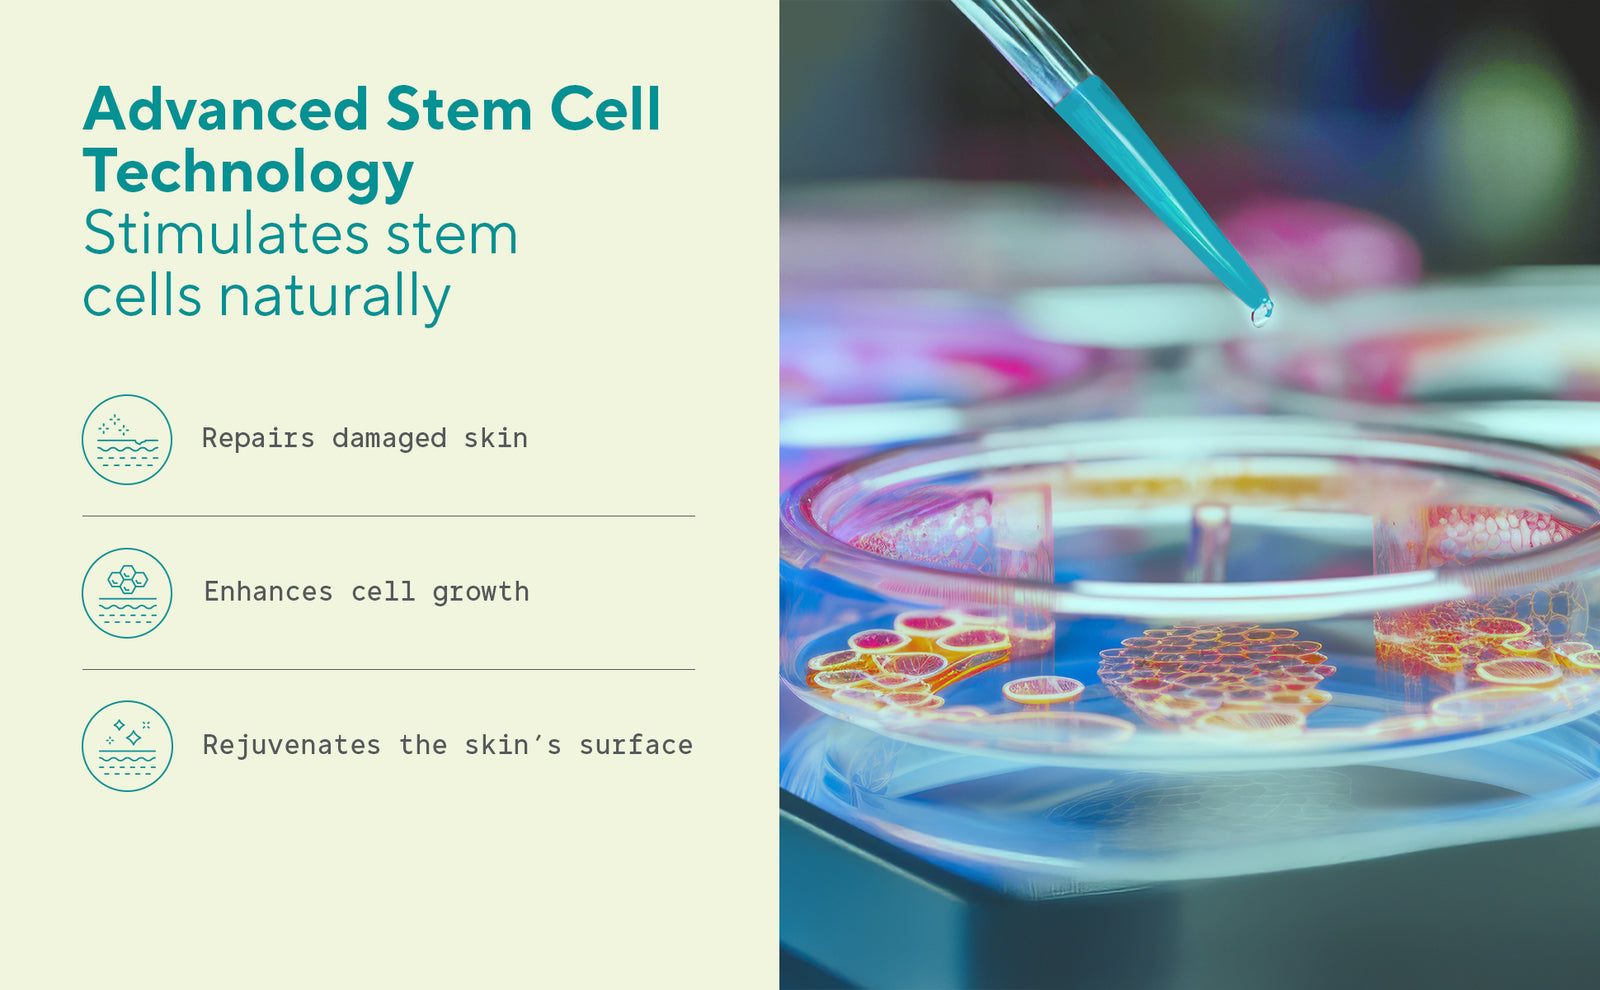

EqualsTwo Skin Healing Cream (150 gm, Carton)
EqualsTwo Skin Healing Cream (150 gm, Carton)
Regular price
₹ 616
Sale price
₹ 616
Regular price
₹ 649
5% off
(inclusive of taxes)
Shipping calculated at checkout.
EqualsTwo Skin healing cream is a 100% Natural coconut based cream enriched with natural ingredients which help in reducing dryness and provide relief from eczema
Overview
Overview
Ingredients
Ingredients